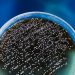

HILLSBOROUGH COUNTY, Fla. (WFLA) — The school board of Hillsborough County, Florida, held a special meeting on Tuesday and voted to ban a book from all public middle schools in the area.
The book, titled “This Book Is Gay”, explores a number of topics, including stereotypes and “coming out.” Advocates and the book’s author say it was written to help young people who are beginning to explore their sexuality.
Controversy over the book began last year when a parent filed a complaint because the book was available in the Pierce Middle School library in Tampa. A committee at the school reviewed the book and decided it should stay. Their decision was appealed, and then a district committee reviewed the book, and also voted that it could remain on library shelves. That decision was appealed, leading to Tuesday’s special school board meeting.
Italian mayor invites Florida parents to see David sculpture after uproar
More than 60 people showed up to the meeting to discuss both sides of the issue. Critics argued it wasn’t age-appropriate for middle school students.
“This book has to go. I’m a grandmother and I don’t want my grandchild reading this book,” one woman said.
“I never saw a book like this in the library when I was in school,” said attendee Terri Rock, who added that she felt the book is “grooming children.” As defined by the Rape, Abuse & Incest National Network (RAINN), the word “grooming” refers to “manipulative behaviors that [a sexual abuser] uses to gain access to a potential victim, coerce them to agree to abuse, and reduce the risk of being caught.”
Over the past two years, the LGBTQ+ community has faced targeted accusations of “grooming” from some far-right and conservative groups, though the Anti-Defamation League notes the language is not used legitimately. “Instead, [anti-LGBTQ+ figures] imply or explicitly claim that LGBTQ+ people are pedophiles who are preying on children by discussing issues related to sexual orientation and gender identity.”
Back in Hillsborough County, others who spoke during the meeting fear that banning books sets a bad precedent.
Book ban attempts hit record high in 2022, library org says
“I may not agree with a content, but others might,” said one student. “And how is it my decision to choose what is to be read and what is not?”
“Very upsetting, and very scary. This, that’s a very scary precedent for our future of books,” said library media specialist Kathleen Daniels.
At the end of the meeting, the board voted 4-3, agreeing that the book was not age-appropriate and did not belong in middle schools.
“For us to have a book is so sexually explicit in the hands of children, minors, that is what is upsetting and concerning to me,” said School Board Member Stacy Hahn, who represents District 2.
“This Book Is Gay,” written by British author Juno Dawson, was first published in 2015. The award-winning bestseller is recommended for grade levels 8-12 and reading ages 14-17.